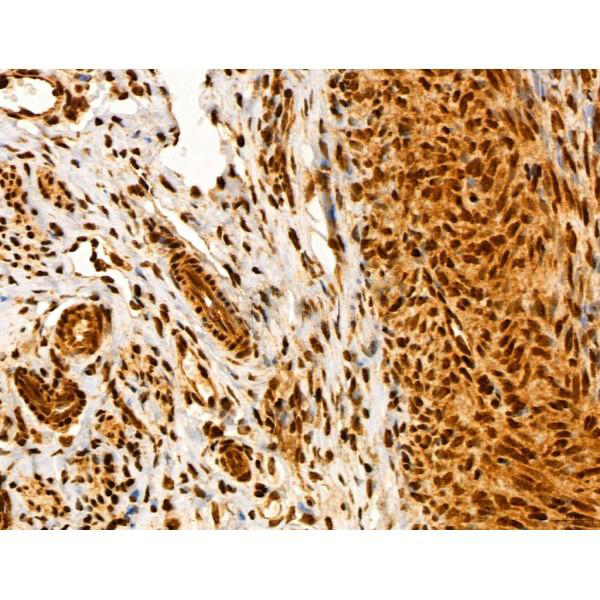

Component of the 26S proteasome, a multiprotein complex involved in the ATP-dependent degradation of ubiquitinated proteins. This complex plays a key role in the maintenance of protein homeostasis by removing misfolded or damaged proteins, which could impair cellular functions, and by removing proteins whose functions are no longer required. Therefore, the proteasome participates in numerous cellular processes, including cell cycle progression, apoptosis, or DNA damage repair. Within the complex, functions as a proteasomal ubiquitin receptor. Engages and activates 19S-associated deubiquitinases UCHL5 and PSMD14 during protein degradation. UCHL5 reversibly associate with the 19S regulatory particle whereas PSMD14 is an intrinsic subunit of the proteasome lid subcomplex.
Description
Rabbit polyclonal antibody to ADRM1
Applications
WB, IF, ICC, IHC
Immunogen
ADRM1 Antibody detects endogenous levels of total ADRM1.
Reactivity
Human, Mouse, Rat.
可预测:Zebrafish(100%), Bovine(%), Horse(%), Sheep(%), Dog(%), Chicken(%), Xenopus(%)
Molecular weight
46 kDa; 42kD(Calculated).
Host species
Rabbit
Ig class
Immunogen-specific rabbit IgG
Purification
Antigen affinity purification
Full name
ADRM1
Synonyms
110 kDa cell membrane glycoprotein; adhesion regulating molecule 1; Adhesion-regulating molecule 1; ADRM 1; Adrm1; ADRM1_HUMAN; ARM 1; ARM-1; ARM1; Gp110; hRpn13; M(r) 110,000 surface antigen; Proteasomal ubiquitin receptor ADRM1; proteasome regulatory particle non ATPase 13; Proteasome regulatory particle non-ATPase 13; Regulatory particle non ATPase 13; Rpn13; Rpn13 homolog;
Storage
Rabbit IgG in phosphate buffered saline , pH 7.4, 150mM NaCl, 0.02% sodium azide and 50% glycerol. Store at -20 °C. Stable for 12 months from date of receipt.
Swissprot
Q16186




 产品订购:
产品订购:
 渠道电话:
渠道电话: